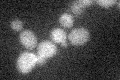
YGL022W
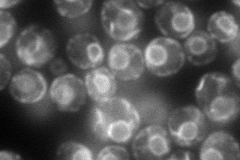
YGL022W
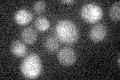
YGL022W

View description
Subunit of the oligosaccharyltransferase complex of the ER lumen, which catalyzes asparagine-linked glycosylation of newly synthesized proteins; forms a subcomplex with Ost3p and Ost4p and is directly involved in catalysis
Localization:
Intensity:
Fold change:
Significance:
-
C’ GFP library in SD
below threshold17.45 -
N' NOP1pr-GFP in SD
ER118.728 -
N' TEF2pr-mCherry in SD

ER55.9116 -
N' NATIVEpr-GFP in SD

missing0 -
N' TEF2pr-VC and Cyto-VN in SD

#N/A0 -
C’ GFP library in SD+DTT

cytosol13.380.76No -
C’ GFP library in SD+H2O2

cytosol16.310.93No -
C’ GFP library in Starvation Media
cytosol16.250.93No -
C’ GFP library on the background of Pup2-DaMP

below threshold -
C’ GFP library on the background of CCT mutant

below threshold15.47740.886678No
